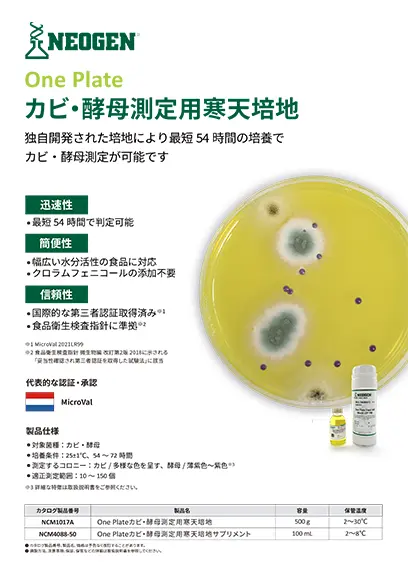
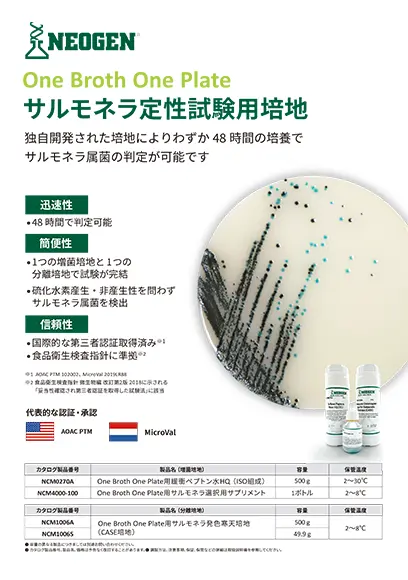

ネオジェンジャパン 製品カタログ一覧
食品、飲料、飼料などでは製造・加工・輸送・購買を含めた様々なプロセスがあります。本ページでは、その各プロセスに対応する品質・安全性向上のための検査ソリューションを提供しているネオジェンジャパン社の製品カタログ(PDF形式)をダウンロードいただけます。
ペトリフィルム™ 培地
病原菌自動検出システム
Megazyme® 食品分析キット&試薬
クリーントレース™ 衛生モニタリング製品
その他
ネオジェンジャパン社について

ネオジェンは、世界各国に拠点を置き、140カ国以上でソリューションを提供しているグローバル企業です。
1982年の創業以来、最先端のテクノロジーと専門的なサービスで世界中の食品安全に関わるお客さまの生産性、安全性の向上をサポートしています。
食品の微生物検査、理化学検査、栄養成分分析など、食品の品質と安全性を効果的で効率的に守るための幅広い製品ポートフォリオを提供しています。
また、製品は国際的な認証を受け、世界中の国々で使用されており、海外輸出製品における検査にも対応しています。
林純薬工業は、ネオジェン製品の日本国内販売代理店として同社製品の取り扱いを行っております。ネオジェン製品に関する各種お問い合わせは、下記から受け付けております。